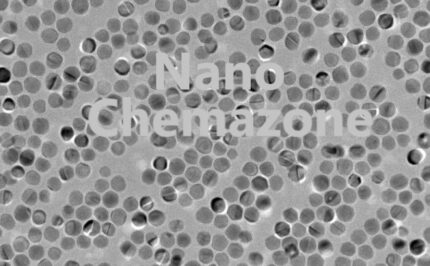
Nickel Nanoparticles

- ANTIMONY SPUTTERING TARGETS
- ANTIMONY TELLURIDE SPUTTERING TARGETS
- Artificial Biological Solutions
- BARIUM FLUORIDE SPUTTERING TARGETS
- BARIUM SPUTTERING TARGETS
- BARIUM STRONTIUM TITANATE SPUTTERING TARGETS
- BARIUM TITANATE SPUTTERING TARGETS
- BARIUM ZIRCONATE SPUTTERING TARGETS
- Aligned MWCNT, >96%
- All Carbon Nanotube Dispersions
- ANODE MATERIALS
- Antibacterial nanoparticles
- BATTERY EQUIPMENT
- BISMUTH FERRITE (INDIUM) SPUTTERING TARGETS
- BISMUTH FERRITE SPUTTERING TARGETS
- BISMUTH OXIDE SPUTTERING TARGETS
- BISMUTH SPUTTERING TARGETS
- BISMUTH TELLURIDE SPUTTERING TARGETS
- BORON CARBIDE SPUTTERING TARGETS
- BORON NITRIDE SPUTTERING TARGETS
- Chromium Nanoparticles
- Bismuth Oxide Nanoparticles
- Boron Oxide Nanoparticles
- Calcium Oxide Nanoparticles
- Cerium Oxide Nanoparticles
- Cesium Tungsten Oxide Nanoparticles
- Bismuth sulfide (biZS3) nanoparticles
- Boron Carbide (B4C) nanoparticles
- Boron Nitride (BN) nanoparticles
- Cadmium Selenide (CdSe) nanoparticles